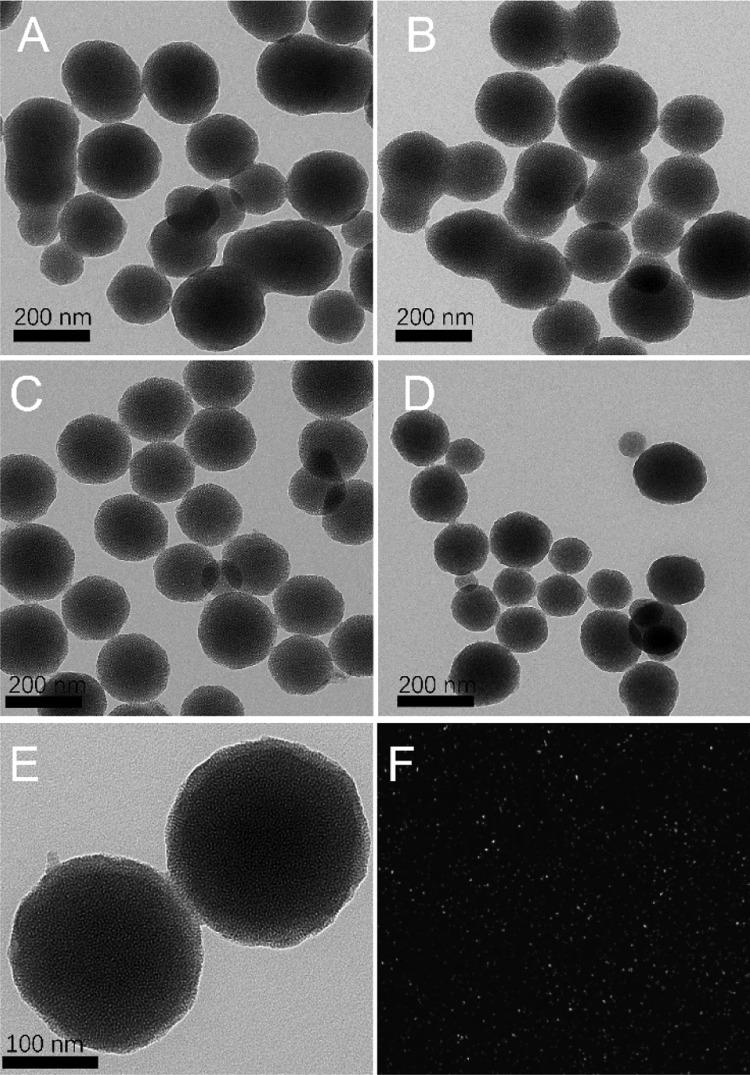

基于免疫荧光碳点/二氧化硅纳米球的侧向流动分析法对严重发热伴血小板减少综合征病毒的超灵敏检测
Ultrasensitive Detection of Severe Fever with Thrombocytopenia Syndrome Virus Based on Immunofluorescent Carbon Dots/SiO Nanosphere-Based Lateral Flow Assay.
作者信息
Xu Lai-Di, Zhang Qing, Ding Shou-Nian, Xu Jing-Juan, Chen Hong-Yuan
机构信息
Jiangsu Province Hi-Tech Key Laboratory for Bio-medical Research, School of Chemistry and Chemical Engineering, Southeast University, Nanjing 211189, China.
Chinese Academy of Inspection and Quarantine, Beijing 100176, China.
出版信息
ACS Omega. 2019 Dec 2;4(25):21431-21438. doi: 10.1021/acsomega.9b03130. eCollection 2019 Dec 17.
Sensitive detection of severe fever with thrombocytopenia syndrome virus (SFTSV) by a point-of-care assay is of great significance for promoting clinical diagnosis. In this work, ultrasensitive detection of SFTSV was achieved by using fluorescent carbon dots/SiO nanospheres (CSNs) as reporters for a lateral flow assay. The prepared CSNs were resistant to extreme environments and had strong stability. The uniform CSNs with the size of about 200 nm were obtained by differential centrifugation. Their absolute quantum yields in the aqueous and solid phases are 56.3 and 36.6%, respectively. The excellent fluorescent properties of CSNs make the test strips more sensitive and have a longer assay lifetime. Thus, the visual detection limit of the lateral flow test strip based on immunofluorescent CSN (iCSN) was as low as 10 pg/mL SFTSV nucleoprotein. The sensitivity of this assay is 2 orders of magnitude higher than that of the colloidal gold-based lateral flow test strip. Besides, the assay owns good reproducibility and high specificity. Then, iCSN-based lateral flow test strips were evaluated in real samples of human serum of patients with satisfactory results. Furthermore, this assay has a general prospect for other fluorescent immunochromatography applications.
通过即时检测法灵敏检测发热伴血小板减少综合征病毒(SFTSV)对促进临床诊断具有重要意义。在这项工作中,通过使用荧光碳点/二氧化硅纳米球(CSNs)作为侧向流动分析的报告分子实现了对SFTSV的超灵敏检测。制备的CSNs对极端环境具有抗性且稳定性强。通过差速离心获得了尺寸约为200 nm的均匀CSNs。它们在水相和固相中绝对量子产率分别为56.3%和36.6%。CSNs优异的荧光特性使测试条更灵敏且检测寿命更长。因此,基于免疫荧光CSN(iCSN)的侧向流动测试条的视觉检测限低至10 pg/mL SFTSV核蛋白。该检测方法的灵敏度比基于胶体金的侧向流动测试条高2个数量级。此外,该检测方法具有良好的重现性和高特异性。然后,在患者人血清实际样本中对基于iCSN的侧向流动测试条进行了评估,结果令人满意。此外,该检测方法在其他荧光免疫层析应用方面具有广阔前景。